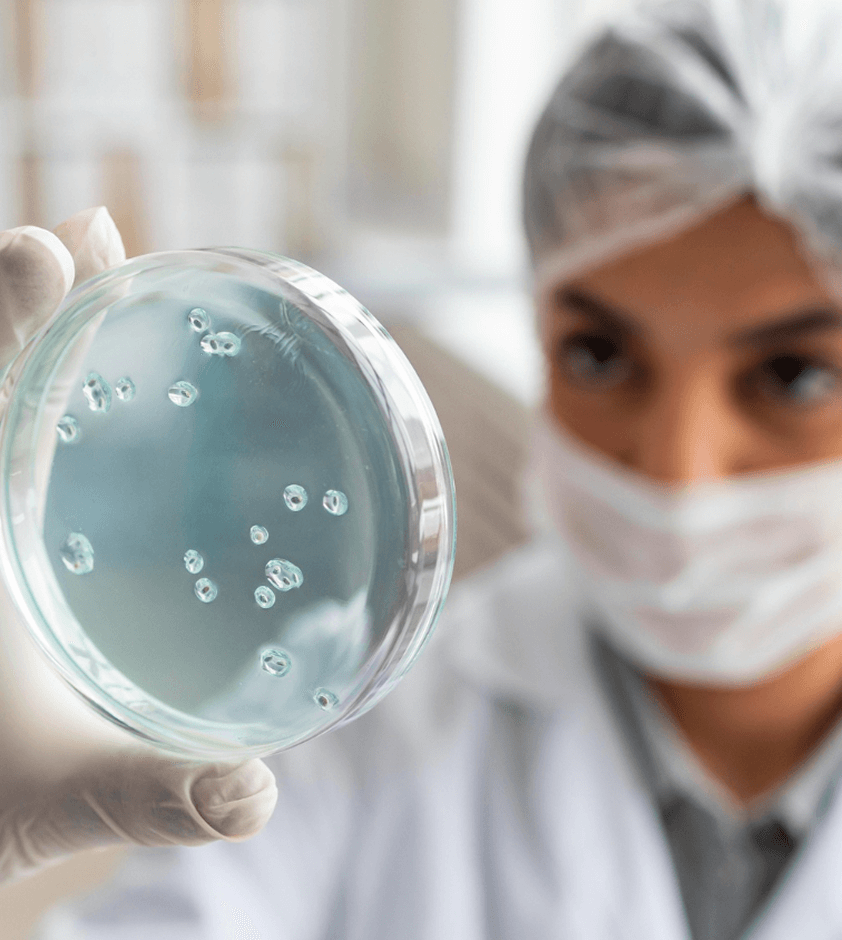
Root cause analysis of microbial contamination (interactive case studies)

Count every Second
Until the Event

QA/QC Head, Formulation Plant

Microbiology Manager

Regulatory Affairs Director

Quality Control Specialist

QA/QC Head, Formulation Plant

Microbiology Manager

Regulatory Affairs Director

Quality Control Specialist
A representation of the event planning of Pharmig 2025
Register your personal data in customer service and take coffee before entering the room.
Why best practices in microbiology are becoming strategic for pharma companies.
The Evolving Landscape of Pharmaceutical Microbiology: Regulation, Innovation, and the Road Ahead.
Contamination Control Strategy (CCS): advantages in using it in a sterile & non-sterile environment.
How does air visualisation fit into your overall microbial control.
Control of microbiological contamination with practical examples & case studies.
Industry Case Insight – Cleaning & disinfection – how does it form part of your Contamination Control Strategy (CCS).
Practical exercises on Microbiology.
Data integrity – what it is and why it is still important.
What Regulators Expects: A Practical View on Microbial Control and CCS Compliance.




Perspectives from international microbiologists

Articles, case studies, and pillar content.

Downloadable insight report

Downloadable 5-episode leadership series, report

Perspectives from international microbiologists

Articles, case studies, and pillar content.

Downloadable insight report

Downloadable 5-episode leadership series, report
powered by
&